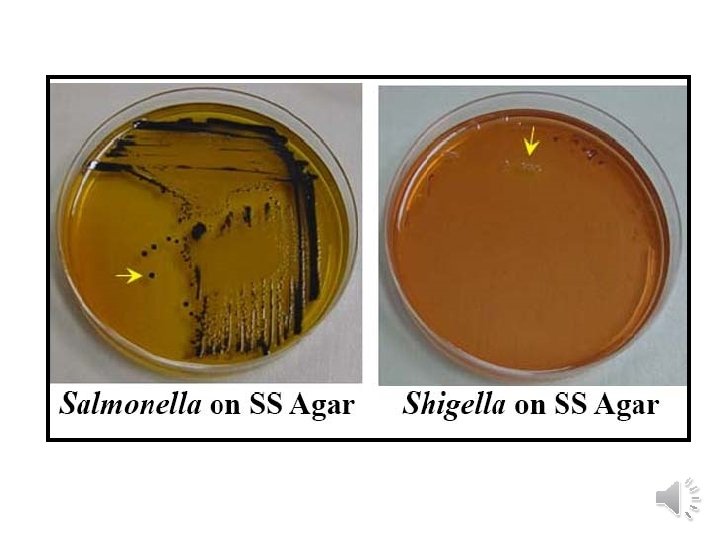
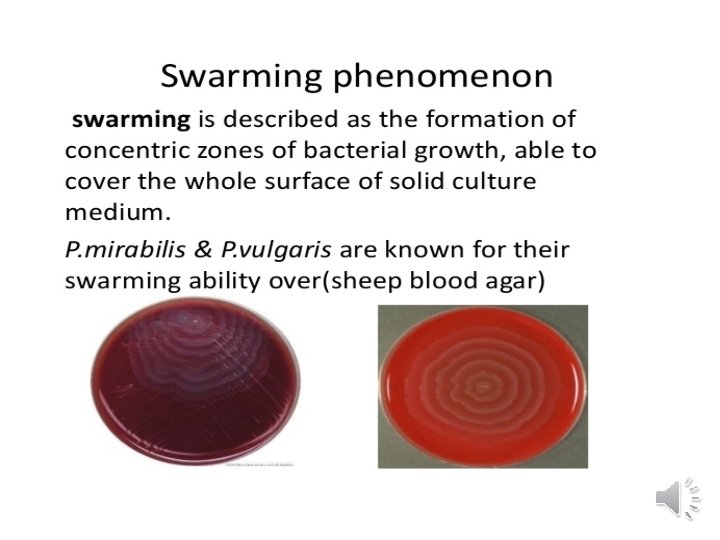

Medical Microbiology Enterobacteriaceae Lab 9 Enterobacteriaceae Enterobacteriaceae includes

Medical Microbiology Enterobacteriaceae Lab. 9

Enterobacteriaceae Ø Enterobacteriaceae includes many genera; Escherichia , Salmonella , Shigella , Enterobacter , Serratia , Proteus , and others are short gram negative rods , non-sporing , facultative an aerobes , catalase positive , oxidase negative. Ø Enterobacteriaceae members are commonly found in the human intestine , either as commensals or as pathogens.

Ø Some tests are used in rapid identification system ; § The production of indole from tryptophan § Triple sugar iron test Ø Culture on differential media contain special dyes and carbohydrates § Mac. Conkey agar § Eosin Methylene Blue agar(EMB) distinguish lactose fermenting from non lactose fermenting colonies.

Identification characters Lactose fermenter bacteria Non-Lactose fermenter bacteria

Escherichia coli • Mac. Conkey agar ( pink colored)-lactose fermenter

• EMB agar (green metalic sheen )

Enterobacter aerogenes • No green metalic sheen on EMB agar. • Often motile. • More viscous colonies.

Mac. Conkey agar EMB agar

Klebsiella pneumoniae • Pink to purple colonies on Mac. Conkey agar • No green metallic sheen on EMB agar. • Non- motile. • Very viscous mucoid colonies.

Klebsiella pneumoniae

Shigella sp. • Non-motile pale colonies on SS agar. • TSI: K/A , H 2 S(-) Salmonella sp. • Motile black colonies on SS agar. • TSI: K/A , H 2 S(+)

Proteus sp. • • Motiler. Swarming on agar. Fishy odor. Urease production

- Slides: 15